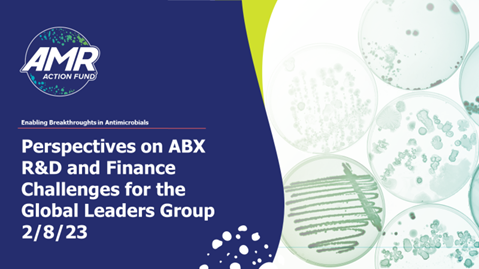
Session 6, Presentation 2, Perspectives on ABX R&D and Finance Challenges

Session 6, Presentation 2, Perspectives on ABX R&D and Finance Challenges
14 March 2023
| Standards
Overview
The sixth meeting of the GLG, Session 6, Presentation 2, Perspectives on ABX R&D and Finance Challenges presentation.
Henry Skinner, Chief Executive Officer, AMR Action Fund, presented an overview of the clinical pipeline for antimicrobials targeting priority pathogens and recommended strengthening the pipeline by addressing the market issues, and strategic investments in antimicrobials as a global public good.
WHO Team
One Health Global Leaders Group on Antimicrobial Resistance
